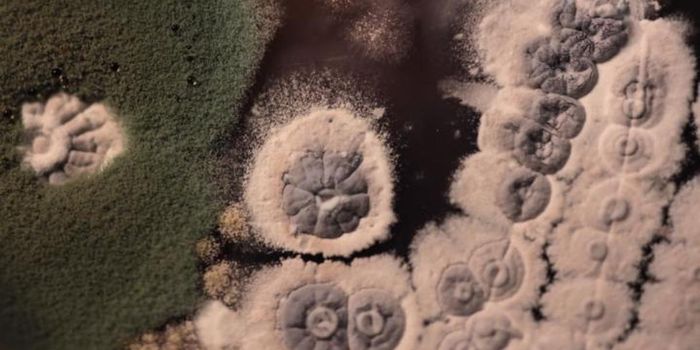
The Long Evolutionary History of Antibiotics and Resistance
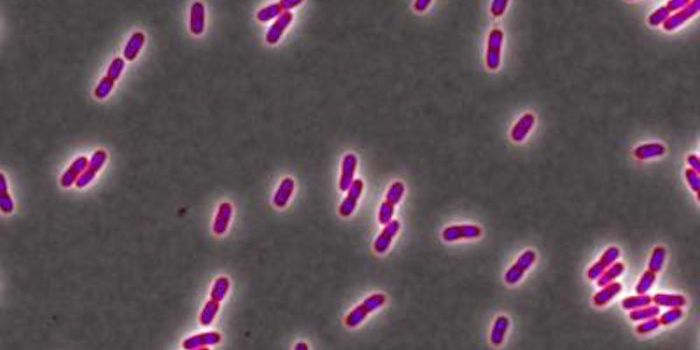
Common Antimicrobial Agent Reduces the Efficacy of Antibiotics

Gene Synthesis
Gene Synthesis: sometimes known as DNA printing[1] is a method in synthetic biology that is used to create artificial genes in the laboratory. Currently based on solid-phase DNA synthesis, it differs from molecular cloning and polymerase chain reaction (PCR) in that the user does not have to begin with preexisting DNA sequences. The method has been used to generate functional bacterial or yeast chromosomes containing approximately one million base pairs.
-
DEC 13, 2020Genetics & GenomicsResearchers led by Professor Carmen Birchmeier at the MDC have used a cutting-edge tool to learn more about different nu ...Written By: Carmen LeitchOCT 01, 2020CancerOne key to understanding cancer metabolomics lies in the ability to accurately replicate the natural environment of the ...Sponsored By: Human Metabolome TechnologiesAUG 18, 2020Genetics & GenomicsScientists have found a cluster of genes that plays a role in the development of an autism subtype. The genes are involv ...Written By: Carmen LeitchAUG 10, 2020Cell & Molecular BiologyWe have known for decades that lead harms the body. This work can help explain how that happens.Written By: Carmen LeitchJUL 10, 2020CancerThe most important part of cancer treatment is the first step, diagnosis. Many cancers can lie dormant for years, reachi ...Written By: Jasper CantrellJUL 05, 2020MicrobiologyThe microorganisms of the world have to compete for survival, and they sometimes do battle with one another. Some use an ...Written By: Carmen LeitchMAY 25, 2020Cell & Molecular BiologyResearchers are challenging what we thought we knew about the mechanism of sexual reproduction.Written By: Carmen LeitchAPR 13, 2020Cell & Molecular BiologyWhile heparin is the most commonly prescribed drug in hospitals, we have to extract it from pig intestines, which is fra ...Written By: Carmen LeitchMAR 09, 2020Genetics & GenomicsThe bacterium Escherichia coli comes in many forms, and researchers have used a harmless strain of it to redesign how th ...Written By: Carmen LeitchFEB 22, 2020TechnologyOur DNA code, that stores all of our genetic information, is stored within our genome. Not only us, but other living org ...Written By: Nouran AminFEB 17, 2020Genetics & GenomicsScientists are learning more about how to use the genetic code to make a synthetic genome with specific biological funct ...Written By: Carmen LeitchFEB 09, 2020Cell & Molecular BiologyThe X chromosome carries a thousand genes, so in females, one of the X chromosomes must be silenced to avoid serious dev ...Written By: Carmen LeitchDEC 04, 2019Cell & Molecular BiologyResearchers have found a drug that can correct the memory and learning impairments that are linked to Down syndrome.Written By: Carmen LeitchNOV 16, 2019Genetics & GenomicsThis work may help develop new treatments for skin that is aging or damaged by wounds or burns.Written By: Carmen LeitchOCT 19, 2019MicrobiologyAround a third of the global population, including 40 million Americans are thought to be infected with a parasite calle ...Written By: Carmen LeitchAUG 18, 2019MicrobiologyThe world is full of bacteria that have to share the world with myriad species, and often have to live in competition wi ...Written By: Carmen LeitchMAY 23, 2019Genetics & GenomicsEvery year, the world consumes around 182 million tons of tomatoes. Yet, thanks to years of genetic editing and crossbre ...Written By: Annie LennonMAY 16, 2019Cell & Molecular BiologyIn a short period of time, researchers were able to engineer an artificial form of microbial life, using relatively simp ...Written By: Carmen LeitchMAR 19, 2019Genetics & GenomicsIt’s the first thing you learn in biology. There are four nucleotides which are adenine, cytosine, gu ...Written By: Amanda MikyskaMAR 01, 2019Cell & Molecular BiologyObesity is now considered an epidemic by WHO; they estimate that 2.8 million people die every year because they are over ...Written By: Carmen LeitchFEB 28, 2019Cannabis SciencesScientists from the University of California, Berkeley, have been able to extract cannabis compounds not from the c ...Written By: Amy LoriauxFEB 24, 2019Cell & Molecular BiologyThe mitochondria is thought of as the cell's powerhouse. It's a special organelle that carries its own DNA and makes its ...Written By: Carmen LeitchFEB 24, 2019MicrobiologyTriclosan is commonly added to many household products and even toys and credit cards so microbial growth will be reduce ...Written By: Carmen LeitchFEB 14, 2019Cell & Molecular BiologyCigarette smokers become addicted to nicotine, a highly addictive substance that is absorbed through the skin, mouth, an ...Written By: Carmen Leitch
DEC 13, 2020
Genetics & Genomics
Researchers led by Professor Carmen Birchmeier at the MDC have used a cutting-edge tool to learn more about different nu
...
Written By:
Carmen Leitch
OCT 01, 2020
Cancer
One key to understanding cancer metabolomics lies in the ability to accurately replicate the natural environment of the
...
Sponsored By:
Human Metabolome Technologies
AUG 18, 2020
Genetics & Genomics
Scientists have found a cluster of genes that plays a role in the development of an autism subtype. The genes are involv
...
Written By:
Carmen Leitch
AUG 10, 2020
Cell & Molecular Biology
We have known for decades that lead harms the body. This work can help explain how that happens.
Written By:
Carmen Leitch
JUL 10, 2020
Cancer
The most important part of cancer treatment is the first step, diagnosis. Many cancers can lie dormant for years, reachi
...
Written By:
Jasper Cantrell
JUL 05, 2020
Microbiology
The microorganisms of the world have to compete for survival, and they sometimes do battle with one another. Some use an
...
Written By:
Carmen Leitch
MAY 25, 2020
Cell & Molecular Biology
Researchers are challenging what we thought we knew about the mechanism of sexual reproduction.
Written By:
Carmen Leitch
APR 13, 2020
Cell & Molecular Biology
While heparin is the most commonly prescribed drug in hospitals, we have to extract it from pig intestines, which is fra
...
Written By:
Carmen Leitch
MAR 09, 2020
Genetics & Genomics
The bacterium Escherichia coli comes in many forms, and researchers have used a harmless strain of it to redesign how th
...
Written By:
Carmen Leitch
FEB 22, 2020
Technology
Our DNA code, that stores all of our genetic information, is stored within our genome. Not only us, but other living org
...
Written By:
Nouran Amin
FEB 17, 2020
Genetics & Genomics
Scientists are learning more about how to use the genetic code to make a synthetic genome with specific biological funct
...
Written By:
Carmen Leitch
FEB 09, 2020
Cell & Molecular Biology
The X chromosome carries a thousand genes, so in females, one of the X chromosomes must be silenced to avoid serious dev
...
Written By:
Carmen Leitch
DEC 04, 2019
Cell & Molecular Biology
Researchers have found a drug that can correct the memory and learning impairments that are linked to Down syndrome.
Written By:
Carmen Leitch
NOV 16, 2019
Genetics & Genomics
This work may help develop new treatments for skin that is aging or damaged by wounds or burns.
Written By:
Carmen Leitch
OCT 19, 2019
Microbiology
Around a third of the global population, including 40 million Americans are thought to be infected with a parasite calle
...
Written By:
Carmen Leitch
AUG 18, 2019
Microbiology
The world is full of bacteria that have to share the world with myriad species, and often have to live in competition wi
...
Written By:
Carmen Leitch
MAY 23, 2019
Genetics & Genomics
Every year, the world consumes around 182 million tons of tomatoes. Yet, thanks to years of genetic editing and crossbre
...
Written By:
Annie Lennon
MAY 16, 2019
Cell & Molecular Biology
In a short period of time, researchers were able to engineer an artificial form of microbial life, using relatively simp
...
Written By:
Carmen Leitch
MAR 19, 2019
Genetics & Genomics
It’s the first thing you learn in biology. There are four nucleotides which are adenine, cytosine, gu
...
Written By:
Amanda Mikyska
MAR 01, 2019
Cell & Molecular Biology
Obesity is now considered an epidemic by WHO; they estimate that 2.8 million people die every year because they are over
...
Written By:
Carmen Leitch
FEB 28, 2019
Cannabis Sciences
Scientists from the University of California, Berkeley, have been able to extract cannabis compounds not from the c
...
Written By:
Amy Loriaux
FEB 24, 2019
Cell & Molecular Biology
The mitochondria is thought of as the cell's powerhouse. It's a special organelle that carries its own DNA and makes its
...
Written By:
Carmen Leitch
FEB 24, 2019
Microbiology
Triclosan is commonly added to many household products and even toys and credit cards so microbial growth will be reduce
...
Written By:
Carmen Leitch
FEB 14, 2019
Cell & Molecular Biology
Cigarette smokers become addicted to nicotine, a highly addictive substance that is absorbed through the skin, mouth, an
...
Written By:
Carmen Leitch